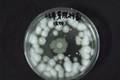

搜索
作品简介: 肉毒梭菌广泛存在于土壤中,对动物尸体旁土壤采用热处理方法,找出对新霉素、卡那霉素、多粘菌素具有抗性的单菌落,染色后镜检选出疑似菌,经生化鉴定确定为C型肉毒梭菌。提取肉毒素后,用蛋白电泳鉴定C型肉毒毒素的重链和轻链的大小分别为98.0KDɑ和53KDɑ,与理论分子量相符。将脱毒后的C型肉毒毒素与弗氏佐剂乳化后免疫家兔,并收集家兔血清。用抗毒素进行琼扩和蛋白印迹实验,检测抗体效价和肉毒素的抗原性。
作品简介: “果园移动式多功能梯的设计”是针对于我国大片果树的修剪、采摘和套袋等工作量大,劳动强度高,分析果树修剪、采摘和套袋的特殊性,设计的一种用于水果采摘、修剪和套袋的梯子,可实现采摘修剪套袋时,人不用下梯而移动梯子,且结构工艺简单,方便实用,以最低的费用减轻劳动强度,增加农民收入。
作品简介: 本设计针对以上述特殊人群,设计的一种多功能汤勺,可准确控制喂药量,同时用其喝汤,吃粥及进食流体食物,方便、高效,也不易将药品、液体液体食物洒出,为特殊群体的喂药、进食提供了一种工具,减轻了家属照顾婴幼儿、老年人、病人的劳动强度,具有很好的社会与经济效益。
作品简介: 普法宣传教育,作为一项宏大的社会系统工程,在华夏大地上自1985年破土动工至今,已有25载。如今已取得举世瞩目的巨大成就,新疆由于社会发展滞后,以及特殊的民族文化背景,普法宣传教育工作比较困难。尤其是南疆部分地区,笔者通过对南疆普法教育的调查研究,为因地制宜的制定南疆普法方案提供参考,促进南疆地区的普法进程,进而为南疆地区的经济发展创造良好的社会环境。
作品简介: 在不断进步与发展的社会中,汽车作为现代人们的主要代步工具,它越来越受到人们的关注。而在今天能源问题已经逐渐凸显,中国汽车未来的发展方向到底应往何处呢?那就是节约能源的汽车.
作品简介: 在对古尔班通古特沙漠南缘的荒漠植物进行现地调查基础上,选取典型植物种类进行荒漠植物的高光谱数据和含水率的测定,对测定的高光谱数据在进行噪声消除后,使用相关分析法,确定荒漠植物光谱数据与含水率之间的关系,找出荒漠植物对水分响应的敏感波段,并对荒漠植物对水分敏感波段的归一化光谱数据进行聚类分析,将测定的荒漠植物按其含水率大小划分为3个等级。
作品简介: 通过游戏引擎RPG Maker XP独立自主设计简洁的游戏剧情,配以独特的游戏背景音乐和轻松,诙谐的游戏对白配音,以游戏关卡的形式融入自然、文化、历史、科学等各个方面的知识问答,并结合游戏剧情将一些时下比较流行的休闲小游戏,如“躲避大考验”、“推箱子”等巧妙的嵌入到整个游戏过程中,自主开发出以角色扮演为基础,益智性、冒险性和娱乐性并重的益智冒险性游戏。作品体现了当代大学生寓教于乐的游戏理念。
作品简介: 石河子市地处我国西北,作为沿天山北疆经济带重要城市之一,其工业化发展和城市化进程均处于国内前列。城市生活垃圾不仅产生量逐年增加,而且成分也变得复杂。石河子市又是“中国优秀旅游城市”并被联合国评为“最适宜人类居住城市”。因此,我们在这方面所做的研究与努力,对其城市环卫事业的发展规划具有借鉴意义。
作品简介: 针对农八师石河子市幼儿教育资源配置方面存在的问题,旨在摸清现状,寻找适合于农八师石河子市幼儿教育快速、健康发展的对策。本研究进行大量实地调查与访谈,查阅年鉴与文献,在描述农八师石河子市幼儿教育总体发展情况及师资、办学条件配置情况的基础上,把公办园与民办园的师资、办学条件进行了对比分析,反映农八师石河子市幼儿教育资源配置整体现状。通过调查研究及对现状的分析,发现问题,分析成因,提出对策建议。
作品简介: 本作品针对石河子大学机电学院研制的6SF-40型番茄色选机的正式上线进行实际生产调试实验,利用校企合作项目的机会,通过结构创新,利用现代设计理论和方法,设计开发出了一台新型高效、分选精度高、结构简单、操作方便的加工番茄自动分选试验台。
作品简介: 本作品针对现有土槽在水分、盐分测定应用过程中的种种弊端(水分和盐分不能同时监测,在土槽测试盐分时容易对土样扰动、实验工作量大、出现误差几率高等),改进创新。改进后的装置具有如下优点:1、实现了水盐测试装置对土壤任意点水分、盐分实时测定;2、可以方便地描绘土壤湿润峰曲线,结合时域反射仪可以同时描绘盐分变化曲线,利于对水盐运动机理的描述;3、提高了实验效率、减少了实验误差出现的几率、节省试验成本。
作品简介: 本作品瞄准当前人类健康和食品安全的热点问题,利用先进、环保、绿色的现代分离方法和技术对新疆特色优质资源沙枣中的多酚类物质的制备进行系统研究,开发出具有廉价、绿色、高效等优点的新型天然抗氧化剂。
作品简介: 本论文选取石河子垦区为研究区域,以中巴卫星影像和土地利用现状图为基础,运用遥感图像处理技术对研究区域植被进行了分类,计算了各类植被面积的转移矩阵,确定了石河子垦区不同植被生态需水定额量,通过面积定额法计算了石河子垦区植被生态需水总量,分析了石河子垦区植被生态需水量的数量变化和空间变化。其结果一方面可为玛纳斯河流域水资源的综合开发和管理提供理论依据;另一方面可为生态需水理论的完善提供一些探索依据。
作品简介: 本次调查是在对十四个师市及农牧团场调研的基础上,分析和总结了新疆生产建设兵团“十一五”科技项目管理的实施情况。本论文是在调查问卷的基础上,对兵团科技项目管理过程的现状做一总结,指出了兵团在科技项目管理过程中存在的问题以及需要改进的方面,提出了完善团场科技计划管理体制的整改措施,给出了兵团在加强新疆生产建设兵团科技计划管理体制方面的建议。
作品简介: 由于新疆少数民族大学生没有及时改进就业观中存在的一些问题,从而导致民族学生在面临就业时困难重重。通过调查,民族学生问题主要是依赖心理较严重,就业预期过于理想化,并且与汉族学生缺乏有效沟通,就业观相对滞后。针对以上存在的问题,建议通过民族生加强与汉族学生交流,学校加强相应指导等方式,改善新疆民族学生就业观中存在的问题与不足,以提高就业竞争力。
作品简介: 石河子市作为兵团最典型的移民地区,人口老龄化问题也日趋明显。本项目首次以石河子市为例,采用自制的人口学统计资料和纽芬兰纪念大学幸福感测量表,对350名60及以上的老年人进行问卷调查,收集数据,并采用SPSS16.0进行数据分析与处理,分析影响石河子市老年人主观幸福感的相关因素。为开展提高老年人心理健康水平及生活质量的社区服务提供理论依据。也对兵团政府有关部门制定和完善老年人相关政策具有参考意义。
作品简介: 以纯化的水霉病原菌作为指示菌,从健康的河鲈的粘液和肌肉中分离筛选水霉拮抗菌,结果得到6株对水霉有较强的拮抗作用,其中HJ010拮抗作用较强,对水霉孢子萌发和菌落的形成都有明显抑制。
作品简介: 本作品通过对矿井通风系统的研究,综合采矿工程、通风系统工程、机械电子工程等多门学科知识,通过信息采集技术和自动化控制技术实现矿井通风的自动化网络调节,实现了井下风门按需自动调控,并且风门开度能根据巷道内危险气体的变化而连续动态变化,主动控制、稀释和降低危险气体含量,既消除了安全隐患又确保了井下通风系统不发生紊乱。从而达到提高通风系统效率,提高煤矿安全管理水平的目标。
作品简介: 作品在深入调查的基础上,研究兵团多元化种植对团场职工收入的影响。通过对兵团农八师团场职工种植业收入现状调查分析、对比不同农作物种植的基本情况及影响收入的因素,分析多元化种植对团场职工收入的影响,并结合兵团农业结构调整政策,对多元化种植提供参考依据和建议。
作品简介: 把“适宜居住,适宜创业,适宜旅游”作为发展战略,以特色产业和各景区为动力。通过发展生态旅游不仅可以促进农业增效、农民增收,推进团连跨越式发展和社会主义新农村建设的重要力量。通过我们的理论分析和实地调查,总结出更为可行,更为有效的发展方案,以石河子桃源生态旅游区为试点,逐渐向全疆乃至全国推广。